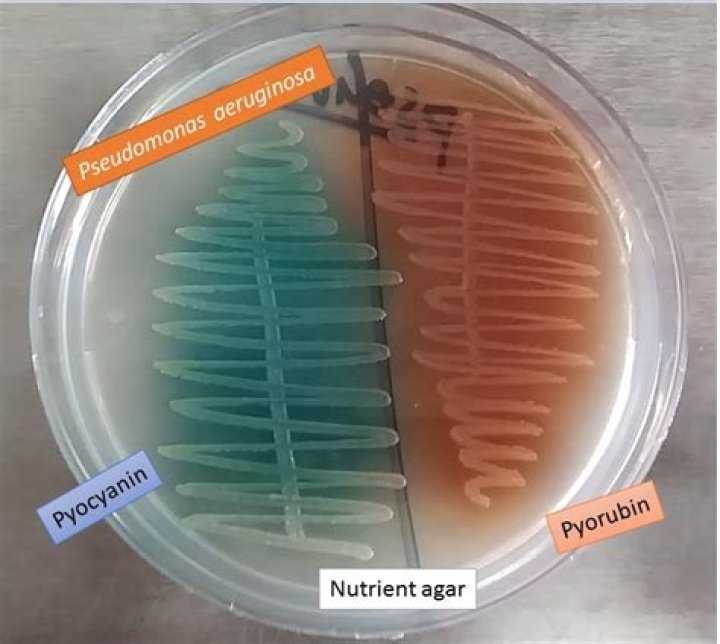

Why is pseudomonas blue-green
This blue-green pigment is a combination of two metabolites of P. aeruginosa, pyocyanin (blue) and pyoverdine (green), which impart the blue-green characteristic color of cultures.
Why does Pseudomonas aeruginosa have a green Colour on nutrient agar plates?
Pseudomonas aeruginosa is a type bacteria it produce the pyoverdine and the pyocyanine pigments on a nutriment culture. the pigment is in green color.
Is pseudomonas a green drainage?
If it’s in a wound, there may be green-blue pus in or around the area. If you have swimmer’s ear, your ear aches. If the infection causes pneumonia, you may get a cough. When the infections are elsewhere in the body, you may have a fever and feel tired.
What color pigment does Pseudomonas aeruginosa produce?
P. aeruginosa produces pyocyanin (N- methyl- 1- hydroxyphenazine) which is a water soluble blue-green phenazine color pigment produced in large quantities12. Despite of its antimicrobial and other commercial significant properties, there are reports that the bacterium P.What Colour is Pseudomonas?
One of the defining attributes of Pseudomonas aeruginosa is its striking blue-green color.
What does Pseudomonas aeruginosa look like?
Pseudomonas aeruginosa is a Gram-negative, rod-shaped, asporogenous, and monoflagellated bacterium. It has a pearlescent appearance and grape-like or tortilla-like odour. P. aeruginosa grows well at 25°C to 37°C, and its ability to grow at 42°C helps distinguish it from many other Pseudomonas species.
Is Pseudomonas prokaryotic or eukaryotic?
Background. The genome of Pseudomonas aeruginosa contains at least three genes encoding eukaryotic-type Ser/Thr protein kinases, one of which, ppkA, has been implicated in P. aeruginosa virulence.
How do you identify Pseudomonas aeruginosa on nutrient agar?
28.2: Pseudomonas aeruginosa on nutrient agar showing greenish colouration due to production of Pyoverdin pigment. Pseudomonas produces large, opaque, flat colonies with irregular margins and distinctively fruity odour colonies.What are the characteristics of Pseudomonas?
- Rod-shaped.
- Gram-negative.
- Flagellum one or more, providing motility.
- Aerobic.
- Non-spore forming.
- Catalase-positive.
- Oxidase-positive.
Genus Pseudomonas produces a variety of extra-cellular pigments of which phenazines comprise the most significant one. The most characteristic feature of Pseudomonas aeruginosa is the production of soluble pyocyanin pigment: a water soluble blue green phenazine compound.
Article first time published onHow does Pseudomonas produce pyocyanin?
In order for pyocyanin to be synthesized by P. aeruginosa, two specific genes must be functional. MvfR is a gene which produces a transcription factor which activates phnAB genes. These genes produce the molecule quinolone which then regulates operons 1 and 2 of phzRABCDEFG which are key to the synthesis of phenazine.
What is the color of the pigment Xanthomonadin?
Xanthomonadins are membrane-bound yellow pigments that are typically produced by the phytopathogenic bacteria Xanthomonas spp., Xylella fastidiosa, Pseudoxanthomonas spp., and a range of environmental bacterial species. Xanthomonadins have been studied since the 1970s in the phytopathogen Xanthomonas campestris pv.
What color is Pseudomonas drainage?
Green: Malodorous, sweet-smelling, bright blue-green drainage is often indicative of Pseudomonas infection in the wound. This drainage may thicken and may also appear purulent, in large amounts.
What color is Pseudomonas fluorescens?
P. fluorescens’ are Gram-negative, they will not be purple in the end, but rather red.
What is Pseudomonas for plants?
Plant-associated Pseudomonas live as saprophytes and parasites on plant surfaces and inside plant tissues. Many plant-associated Pseudomonas promote plant growth by suppressing pathogenic micro-organisms, synthesizing growth-stimulating plant hormones and promoting increased plant disease resistance.
Is Pseudomonas Gram positive or negative?
Pseudomonas species are Gram-negative, aerobic bacilli measuring 0.5 to 0.8, μm by 1.5 to 3.0 μm. Motility is by a single polar flagellum. Species are distinguished by biochemical and DNA hybridization tests. Antisera to lipopolysaccharide and outer membrane proteins show cross-reactivity among serovars.
How do you identify Pseudomonas?
Pseudomonas gives negative Voges Proskauer, indole and methyl red tests, but a positive catalase test. While some species show a negative reaction in the oxidase test, most species, including P. fluorescens, give a positive result (Figure 2).
How do you differentiate Pseudomonas aeruginosa and Pseudomonas fluorescens?
The key difference between Pseudomonas aeruginosa and Pseudomonas fluorescens is that the P. aeruginosa is an opportunistic human pathogen while the P. fluorescens is not a human pathogen. More explicitly saying, P.
Is Pseudomonas oxidase positive or negative?
CharacteristicsPseudomonas aeruginosaCatalasePositive (+ve)OxidasePositive (+ve)MRNegative (-ve)VPNegative (-ve)
Does Pseudomonas have nucleus?
We recently demonstrated that the large Pseudomonas chlororaphis bacteriophage 201φ2-1 assembles a nucleus-like structure that encloses phage DNA and segregates proteins according to function, with DNA processing proteins inside and metabolic enzymes and ribosomes outside the nucleus.
Is parasite prokaryotic or eukaryotic?
Parasites are part of a large group of organisms called eukaryotes. Parasites are different from bacteria or viruses because their cells share many features with human cells including a defined nucleus.
What is the characteristic color of P. aeruginosa colonies in BAP?
In the Cetrimide Agar medium, the selective medium for Pseudomonas aeruginosa, colonies are Medium-sized & irregular growth is observed due to the swarming of the bacterium. The pigment production is enhanced and diffused in the medium imparting characteristic greenish-blue coloration to the medium.
Is Serratia motile?
S. marcescens is a motile organism and can grow in temperatures ranging from 5–40 °C and in pH levels ranging from 5 to 9.
What is the Gram stain morphology of Pseudomonas aeruginosa?
Pseudomonas aeruginosa is a Gram-negative rod measuring 0.5 to 0.8 µm by 1.5 to 3.0 µm. Almost all strains are motile by means of a single polar flagellum.
Why is it called Pseudomonas?
Pseudomonas [soo′′do-mo′nəs] From the Greek pseudo (“false”) + monas (“unit”). In 1894, German botanist Walter Migula coined the term Pseudomonas for a genus he described as, “Cells with polar organs of motility.
Why Pseudomonas is named so?
The name Pseudomonas occurred to professor Migula of the Karlsruhe Institute in Germany at the very end of the nineteenth century (Migula, 1894; 1900). His description of the new genus was short and inaccurate but, even so, it was accepted for publication. It reads: ‘Cells with polar organs of motility.
What is the function of Pseudomonas?
Like other members of the Pseudomonas genus, it is known for its metabolic versatility and its ability to colonize a wide range of ecological niches, such as rhizosphere, water environments and animal hosts, including humans where it can cause severe infections.
What bacteria grows green on Macconkey Agar?
OrganismColourRemarksStaphylococcus speciespale pinkopaquePseudomonas aeruginosagreen-brownfluorescent growth
Which media is used for Pseudomonas aeruginosa?
P. aeruginosa grows well on LB broth, but can also utilize a wide range of compounds as sole carbon and/or nitrogen sources. To study growth on these sole nutrient sources, various defined minimal media are used to grow P. aeruginosa such as MOPS (3-(N-Morpholino) Propane-Sulfonic Acid) medium, M9, or M63.
How is Pseudomonas different from Enterobacteriaceae?
aeruginosa is an aerobic bacterium that is known as a common nosocomial pathogen. The key difference between P. aeruginosa and Enterobacteriaceae is that P. aeruginosa is a bacterial species while Enterobacteriaceae is a family of gram-negative bacteria.
Why is Serratia marcescens red?
Serratia marcescens is a gram-negative, facultatively-anaerobic bacterium and opportunistic pathogen which produces the red pigment prodigiosin. … Pigmented cells were found to accumulate ATP more rapidly and to multiply more quickly than non-pigmented cells during the high density growth phase.



